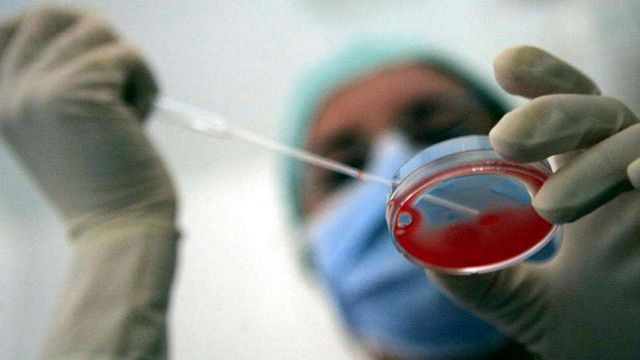

I primi embrioni chimera uomo-scimmia sono ora una realtà scientifica. Sono l'eccezionale risultato della ricerca pubblicata sulla rivista Cell, guidata dall'istituto americano Salk e condotta in collaborazione con la Cina, e nella quale cellule staminali umane sono state trasferite in embrioni di scimmia. Gli embrioni chimera hanno continuato a svilupparsi per 20 giorni.
Per i ricercatori questo risultato è l'occasione per comprendere malattie legate allo sviluppo attualmente impossibili da studiare considerando il limite di 14 giorni alla ricerca sugli embrioni umani. Un passo decisivo verso la futura medicina rigenerativa.
Nell'esperimento 25 cellule staminali umane sono state trasferite in embrioni di scimmia giunti al sesto giorno dello sviluppo. Erano cellule umane pluripotenti indotte, ossia cellule adulte fatte regredire nello sviluppo e in grado di integrarsi sia con i tessuti embrionali veri e propri, sia con i tessuti che aiutano l'embrione a svilupparsi. A distanza di un giorno le cellule umane si erano integrate in 132 embrioni e dopo dieci giorni erano 103 gli embrioni che continuavano a svilupparsi.
Tuttavia dopo questo periodo gli embrioni hanno cominciato ad avere problemi e il loro numero si è ridotto, al punto che dopo 19 giorni solo tre chimere erano ancora vive. Per tutto questo periodo la percentuale di cellule umane negli embrioni è rimasta alta ed è cresciuta costantemente.
"Poiché non siamo in grado di fare alcuni tipi di esperimenti nell'uomo, è essenziale avere modelli migliori per poter condurre studi più appropriati per comprendere la biologia umana e le malattie", osserva il coordinatore della ricerca Juan Carlos Izpisua Belmonte, del Laboratorio di Scienze biologiche dell'Istituto Salk. Allo studio hanno collaborato Università Cattolica San Antonio de Murcia, University of Texas Southwestern Medical Center e Kunming University of Science and Technology.
Quelle uomo-scimmia non sono le prime chimere ottenute finora: la storia di esperimenti di questo tipo è cominciata fin dagli anni '70, ma "storicamente la generazione di chimere animali-uomo ha portato a risultati poco efficienti per quanto riguarda l'integrazione delle cellule umane nella specie ospite", aggiunge Izpisua Belmonte.
Sono invece incoraggianti le analisi condotte finora sugli embrioni chimera sopravvissuti e l'obiettivo a lungo termine è utilizzare le chimere non solo per studiare lo sviluppo embrionale umano e l'origine di molte malattie, ma avere nuovi strumenti per sperimentare farmaci e generare cellule e organi per i trapianti. Quanto alle preoccupazioni etiche, Izpisua Belmonte osserva che "la nostra responsabilità come scienziati condurre la nostra ricerca in modo ponderato, seguendo tutte le linee guida etiche, legali e sociali esistenti".